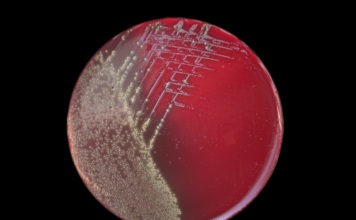
ANSA: vaccino pertosse causa contagio

Vaccini: il Piano Globale
Vaccinazioni, Ordine Sanitario Mondiale
Vaccinazione per tutta la vita, vaccinazione in tutte le farmacie, le scuole, sui posti di lavoro o nei supermercati: una politica di...
Resoconto senato n. 781 del 19.07.2017 – Prevenzione vaccinale Ddl N....
Decreto Lorenzin - Pubblichiamo resoconto sommario della seduta diurna del 19 Luglio 2017 riguardante il Disegno di Legge N. 2856 Conversione in legge del...
Medici e sanitari dicono “NO” all’obbligo vaccinale
Chi l'avrebbe detto. I medici si oppongono all'obbligo vaccinale definendolo incostituzionale. La notizia trova poco spazio sui giornali ma non sfugge ai genitori per...
12 vaccini obbligatori, sanzioni ed esclusione da asili
Su pressione del ministro della salute Beatrice Lorenzin, che di questo ha fatto una sua crociata personale, il Consiglio dei ministri ha dato l’ok...
FASCICOLO DDL S. 2856 Decreto vaccini
Senato - Iter sulla "Conversione in legge del decreto-legge 7 giugno 2017, n. 73, recante disposizioni urgenti in materia di prevenzione vaccinale"
PDF AGGIORNATO IN...
Resoconto senato n. 782 del 19.07.2017 – Prevenzione vaccinale Ddl N....
Decreto Lorenzin - Pubblichiamo resoconto sommario della seduta pomeridiana del 19 Luglio 2017 riguardante il Disegno di Legge N. 2856 Conversione in legge del...
Assenza vaccino antitetano: interrogazione urgente in Senato
Di seguito il testo dell’interrogazione parlamentare presentata dal Senatore Maurizio Romani al Ministro della salute in merito alla scomparsa del vaccino antitetano monocomponente.
12ª Commissione...
Grande fiaccolata a Genova per “Vaccini Sicuri e Libertà di Scelta”
Qualche voce neutrale in rete comincia a farsi sentire, dedicando al movimento per la libertà di scelta vaccinale piccoli spazi e articoli di cronaca...
Emofilo influenza B (Hib): Istituto Superiore di Sanità si contraddice
a cura della redazione AsSIS
Il documento dell’Istituto Superiore di Sanità sull’impatto sulla popolazione delle 12 malattie oggetto degli obblighi vaccinali previsti dal decreto Lorenzin...
Nuovo DDL Disposizioni in materia di prevenzione vaccinale 2018
E' uscita la proposta del nuovo DISEGNO DI LEGGE - "Disposizioni in materia di prevenzione vaccinale". Invitiamo gli utenti a leggerlo e valutarlo con spirito...
Resoconto senato n. 476 del 10.07.2017 – Prevenzione vaccinale Ddl N....
Decreto Lorenzin - Pubblichiamo resoconto sommario della seduta notturna del 10 Luglio 2017 riguardante il Disegno di Legge N. 2856 Conversione in legge del...
Morbillo: immunità di gregge in Mongolia non funziona
La Mongolia è il paese con la più bassa densità di abitanti al mondo, appena 3,2 milioni di persone (concentrata per lo più a Ulaanbaatar)....
Vaccini, posizione della Rete di Sostenibilità e Salute
COMUNICATO STAMPA DEL 29 MAGGIO 2017 Rete di Sostenibilità e Salute
Ci troviamo oggi di fronte a una vera battaglia sul tema delle vaccinazioni,...
VACCINI & EMA – Lo scandalo dei vaccini scomparsi
I vaccini obbligatori raccomandati per i recuperi vaccinali di bimbi e ragazzi scompaiono dal sito dell'agenzia europea dei medicinali, l'EMA. Intere sezioni con tabelle, documenti...
AVVISO: esavalente pediatrico Hexyon, Aifa cancella posologia su scheda vaccino
Appena approvato il decreto vaccini la farmacovigilanza italiana (AIFA) cancella dalla scheda del vaccino esavalente HEXYON i dati relativi all'età di somministrazione e ai...
Audizione senato 20.06.2017 Prevenzione vaccinale Ddl N. 2856
Pubblichiamo il documento che l’Associazione COMILVA Onlus ha presentato in Senato alla Commissione Igiene e Sanità il 20.06.2017, riguardante il Disegno di Legge N....
Vaccini senza adiuvanti! Dal veterinario
Le campagne di vaccinazione veterinaria "su misura" sottolineano l’importanza di una
protezione vaccinale senza adiuvanti. Minore infiammazione, minori rischi.
"Ridurre l’infiammazione nel punto di iniezione è...
LEGGE 119/2017 – Obbligo vaccinale
Testo di legge 119/2017 in materia di vaccini obbligatori del 31 luglio 2017, pubblicato in Gazzetta Ufficiale il 5 agosto 2017.
Il numero completo della...
LEGGE 210/92 – Indennizzo danneggiati da vaccinazioni
Evoluzione della Legge 210/92 e come fare domanda di indennizzo. Testo integrale ed elenco documentazione utile disposta dal sito Comilva.org.
LEGGE 210/92: "Indennizzo a favore...
Quanti sono i danneggiati da vaccino in Italia? Senato risponde.
Quanti sono i danneggiati da vaccino in Italia con sentenze di indennizzo? Quante le posizioni chiuse in seguito a decesso e quante cause ancora...
Sanità italiana e corruzione: dall’attentato Anselmi a De Lorenzo
Tina Anselmi fu la prima donna a diventare ministro in Italia. Integerrima democristiana, dedita al lavoro, s'occupò di previdenza sociale, igiene e sanità. Al...
Vaccini e tutela legale per bambini 0-6 anni
Come tutelare i bambini da 0 a 6 anni a fronte della Legge 119/2017 sui vaccini? Consigli legali e prime linee guida per intraprendere...
Vaccini ai militari: “Commissione Inchiesta Uranio impoverito” conferma tesi freevax
Pubblichiamo integralmente l'articolo di AsSIS - "L’approvazione del Decreto vaccini è coincisa con la pubblicazione della Relazione della Commissione d’inchiesta sull’uranio impoverito, che ha...
HPV: La grande battaglia si combatte ora!
Una delle domande più difficili che i genitori affrontano è: vacciniamo i nostri figli? Per alcuni la risposta è immediata, per altri no. Alcuni genitori...
Legge vaccini, sindaci biellesi: richiesti anticorpali e scuole aperte a tutti!
Sindaci biellesi in prima linea contro i rischi vaccinali e la discriminazione, consapevoli della necessità di accurate indagini e delle controindicazioni, portano in Regione...
Immunità di gregge, USA-CDC conferma: ogni malattia ha soglia diversa
di AsSIS - Il decreto Lorenzin è nato non per un’emergenza (negata dallo stesso Presidente Gentiloni) ma per l’urgenza rappresentata dal calo delle coperture...
ANSA: vaccino pertosse causa contagio
Il vaccino contro la pertosse non impedisce al soggetto vaccinato di diffondere l'infezione a soggetti non vaccinati e neonati, lo afferma un accreditato studio della...
INVENTORI DI MALATTIE – Documentario RAI sulla mafia farmaceutica
VIDEO RAI - Come l'industria farmaceutica "crea" le malattie e miete nuove vittime. Ce lo racconta il giornalista Silvestro Montanaro nel programma RAI "C'era...
MORBILLO A SAMOA: cause dell’alta mortalità. Confronto epidemia 2019/1894
I morti di morbillo nelle Isole Samoa hanno occupato le prime pagine di tutti i quotidiani mondiali da ottobre a dicembre 2019. Poca luce...
“VACCINI, OLTRE L’OBBLIGO” – Incontro con il Dr. Miedico a Alessandria
23 ottobre, ore 21.00
“VACCINI, OLTRE L’OBBLIGO” - Incontro con il Dott. Dario Miedico
Teatro Ambra, via Brigata Ravenna 8, Alessandria
24 ottobre, ore 10.00
CONFERENZA STAMPA -...